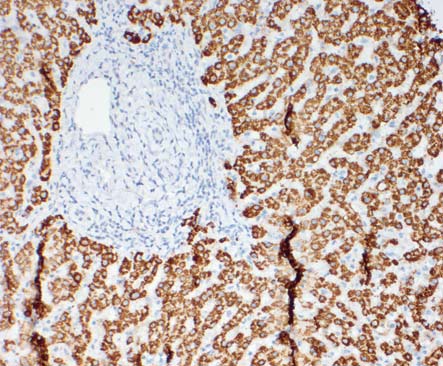
app23

Gigatome Polycut-Legacy Büyük Boy Mikrotom Cihazı
Gigatome PolyCut-Legacy Büyük Boy Mikrotom Cihazı “Almanya’da Üretilmiştir”.
Gigatome Ekip olarak bu alanda ve yakın çevresindeki diğer alanlarda 100 yılı aşkın deneyime sahip bir firmadır.
Bizim için diğer şirketlerden farklı olarak müşteri ve memnuniyeti felsefemizin her şeyden önce gelir. Almanya dışında ucuz ve kaliteli üretim yaparak kâr marjımızı en üst düzeye çıkarmayı önemsemiyoruz. Tüm hedeflerinize maksimum mükemmellikte ulaşabileceğiniz dünyanın en yüksek hassasiyetli mikrotomlarını sunuyoruz.
Hayal bile edemeyeceğiniz boyutlarda numuneler kesmenizi mümkün kılan son derece hassas makinelerle size çözüm sunuyoruz.
Daha fazlasını öğrenmek istiyorsanız bizimle iletişime geçin!

Gigatome Polycut-Legacy Mikrotom
Gigatome Polycut-Legacy, standart mikrotomların zorlandığı daha büyük numunelerin kesilmesi için tasarlanmıştır.
Tüm vücut kesitleri, göz küreleri veya beyin gibi tam organ örneklerinin yanı sıra insan böbreği, karaciğer ve prostat bezi gibi diğer biyolojik dokuların kesitleri için de idealdir.
Ayrıca, malzeme bilimi alanında da geniş bir uygulama yelpazesine sahiptir. Deniz altı kabloları, havacılık ve uzay bileşenleri, borulama sistemleri, otomotiv parçaları, kaplama malzemeleri, güç kabloları, dişliler, karbon fiberler ve cam fiberler gibi farklı endüstriyel örneklerin hassas kesiminde kullanılabilir.
Kompakt boyutuna rağmen, Gigatome Polycut-Legacy masa tipi mikrotomu yüksek hassasiyet, dayanıklılık ve kullanıcı dostu kontrol özellikleriyle öne çıkar. Dokunmatik ekranlı sezgisel kontrol ünitesi, hassas ayar düğmeleri ve döner tekerleklerle donatılmıştır.
Temel Avantajlar
-
Sezgisel dokunmatik ekran kontrolleri
-
Kompakt tasarımlı masa tipi mikrotom
-
Manyetik XY yönlendirme sistemi
-
Yüksek hassasiyetli DC ve step motorlar
-
Birinci sınıf çapraz makaralı kılavuzlar
-
Düşük bakım gerektiren sağlam yapı
-
Mükemmel stabilite sağlayan 80 kg metal gövde
Teknik Özellikler
-
Mikrotom: 250 x 390 x 750 mm (YxGxD) / 80 kg
-
Kontrol Paneli: 180 x 350 x 320 mm (YxGxD) / 10 kg
-
Çalışma Alanı Gereksinimi: 1000 x 950 mm
|
Life Sciences Kesitler
|
|
Material Sciences Kesitler
|
Müşterilerimiz Kimlerdir?
Klinikler, Patoloji Enstitüleri, Araştırma Laboratuvarları ve tanınmış Üniversitelerin yanı sıra, sektördeki müşterilerimizin referanslarından bir alıntıdır:
0
3M GmbH ABB, Abb Vie GmbH, Adidas, Adient PLC, AEG, Aesculap AG, Agfa-Gevaert, Airbus AG, Aisin, Akzo Nobel, Amplifon, A.Raymond, Audi AG, Abbot GmbH
B
BASF SE, Bang & Olufsen, Basell, Bayer AG, Bauer, Bayer Schering AG, B.Braun Melsungen AG, Becton-Dickinson, Beiersdorf AG, Benteler AG, BMW AG, Böhringer, Boing, Bombardier, Bosch GmbH, Borealis, Borg Warner, BP, Bridgestone, Brillux, Bristol Myers Squibb, Brose GmbH, Bruker GmbH, Bundeskriminalamt BKA, Bundeswehr, BYD
C
Canon, CATL, Celanese, Continental AG, Covestro AG, Cromology
D
Dacia, Daimler AG, Daimler Truck AG, Dassault Aviation, DAW, Dekra, Delrin, Denso, Deutsche Bahn AG, De Longhi, Dornier, Dow Europe GmbH, Du Ponmt de Nemours, Du Pont International Sarl, Deutsches Luft- und Raumfahrtzentrum DLZR, Drägerwerk
E
EADS GmbH, Eberspächer, Embraer, Engie Laborelec, EON, Epson, Evonik GmbH, Exxon Mobile
F
Faurecin, Fiat, Fischer GmbH, Fisher Scientific, Ford, Forvia SE, Fresenius GmbH, Fraunhofer Institutes, Furukawa Electric, Fuji, Fujitsu Siemens
G
Gardena AG, Geely, General Electric, GE Medical Systems, General Motors, Gemeral Motors Powertrain GmbH, Gestamp, Giesecke + Devrient, Glaxo-Smith-Kline, Goodyear, Grob Aerospace
H
Hans Grohe, Heckler & Koch GmbH, Helmholtz Institutes, Hempel, Hengtong Group, Henkel AG, Hexatronic, Hilti, Hitachi, Hofmann La Roche AG, Honda, Hongzhou Cable, Hoover, HP, Hyundai, Hyundai Mobis
I
Infineon
J
Jansen Cilag AG, Jenoptik AG, Johnson & Johnson, Jotun
K
Karl Wörwag, KaVo, Kawasaki, Knorr-Bremsen AG, Krauss Maffei AG
L
Leibniz Institutes, Leica Biosystems, Leifheit, Leoni GmbH, Liebherr Aerospace, LG Electronics, LS Cable & System Ltd, Lufthansa AG
M
Magirus, Magna, Mahle, MAN, MAN Nutzfahrzeuge AG, Max-Planck-Institutes, Mazda, Mercedes-Benz AG, Merck KGaA, Michelin, Miele & Cie. KG, Mitsubishi, Mitsui Chemicals, MTU Aero Engines
N
Nestlé AG, Nexans, Nissan, Nokia, Novartis AG
O
Olympus GmbH, Opel AG
P
Panasonic, Panasonic Automotive, Physikalisch-Techniche-Bundesanstalt, Pirelli, Pfizer, Pioneer, Plastic Omnium, Porsche AG, Pratt & Whitney, Procter & Gamble GmbH, Prysmian Group
R
Rehau, Renault, Rhein Metall AG, Rolls Royce AG, Roche, Roto, RWE Power AG
S
Safran S.A., Samsung, Sanofi-Aventis, Schaeffler GmbH, Schott AG, Seat, SGL Carbon GmbH, Shell AG, Siemens AG, Siemens VDO Automotive, Silit, Skoda, Slee Medical GmbH, Solvay, Sony, Storz, Stryker, Sumitomo Electric Industries Ltd., Suzuki
T
Telecom AG, Tetra Pak, Textron Aviation, Thales, Thermo Fisher, Thyssen Polymer, Thyssen-Krupp, Trumpf, T-System Cables, Toshiba, Toyota, Toyoda Gosei, TÜV
U
Uvex Group
V
Valeo, Volkswagen, Volvo
W
Webasto, Wegmann Automotive, Weichai Power, Wieland Werke, Würth
Y
Yamaha, Yazaki, Yokohama Rubber
Z
Zeiss AG , ZC Rubber, ZF Friedrichshafen AG